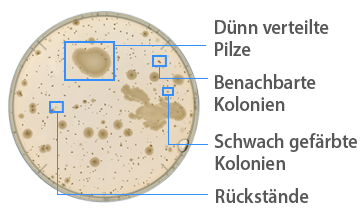
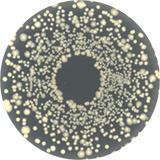

-
Bisherige Methoden

-
BC-1000

Zuverlässige, automatische Zählungen
Eine reproduzierbare Erkennung ist mit einer Präzision von 99% selbst bei kleinsten Kolonien möglich. Eine präzise Zählung ist sogar bei Proben möglich, die mit bisher eingesetzten Methoden nicht leicht zu zählen waren.
Ermöglicht wird dies durch die folgenden KEYENCE-Technologien:
- Hochpräzises Objektiv mit großer Blende
- Gleichmäßige Beleuchtung für eine präzise Erkennung
- Ausschluss von Rückständen
- Kolonienklassifizierung anhand von Merkmalen wie Farbe, Form und Glanz